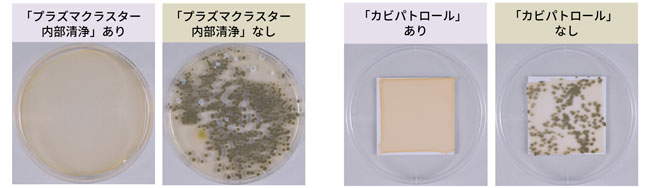

シャープは、2027年度を目標とする新省エネ基準を全機種で達成した、プラズマクラスターエアコン<Rシリーズ>8機種を発売します。

プラズマクラスターエアコン<AY-U40RL2>
本シリーズは、カビの増殖を抑制(※1)する「防カビカラッとファン」を新たに搭載しました。開発にあたり、真菌類研究の権威である県立広島大学の森永力名誉教授監修のもと、エアコン内部で特にカビが多く発生するのは「ファン」であることを解明。カビ対策として、業界で初めて(※2)ファンに「超親水ナノコーティング」を採用。カビの除菌性能を有することに加え、ファンの表面に残った水分を薄く広げることで速乾性を高め、カビ増殖の根本原因となる水分やホコリの付着を抑制します。また、当社独自の空気浄化技術「プラズマクラスター」をエアコン内部に充満させる、「プラズマクラスター内部清浄」や「カビパトロール」機能が進化しました。運転停止後や停止中にも、エアコン内部をイオンで満たし、送風路のカビを除菌(※1)します。これらの機能でエアコン内部を清潔に保つことで、エアコンから吹き出す風に含まれるカビを99.0%以上減少させます(※1)。赤ちゃんにとっても清潔で安心な空気をお届けするという想いを込め、「First Air~はじめての空気を、もっとやさしく~」をキーメッセージとして展開してまいります。
さらに、本シリーズはエアコンで初めて(※3)生成AIサービスに対応しました。スマートフォンなどで、「COCORO HOME」アプリ内の「COCORO HOME AI」から使用できます。エアコンの使い方やお手入れ方法をテキストで質問すると、自然な言葉で回答(※4)します。
寝室など、小部屋の広さに適した<AY-U25RS/U22RS>では、室内機本体の奥行と高さを抑え、設置時の圧迫感を軽減。新省エネ基準を満たしながら、2.5kW~2.2kWクラスにおいて、業界最小の高さ249mmを実現(※5)しました。窓上部などの狭いスペースへも設置がしやすいコンパクト設計です。
■ 主な特長
1.「防カビカラッとファン」とプラズマクラスター技術により、エアコン内部のカビを除菌
2.エアコンで初めて、生成AIサービスに対応
3.新省エネ基準を満たしながら、設置性に優れたコンパクト設計<AY-U25RS/U22RS>
|
品名<シリーズ名>
|
形 名
|
畳数の目安
|
希望小売価格
|
発売日
|
月産台数
|
|
暖房
|
冷房
|
|
プラズマクラスター
エアコン
<Rシリーズ>
|
AY-U71RL2
|
19~23
|
20~30
|
オープン
|
2026年
3月12日
|
計2,100台
|
|
AY-U63RL2
|
16~20
|
17~26
|
|
AY-U56RL2
|
15~18
|
15~23
|
|
AY-U40RL2
|
11~14
|
11~17
|
|
AY-U36RL
|
9~12
|
10~15
|
|
AY-U28RL
|
8~10
|
8~12
|
|
AY-U25RS
|
6~8
|
7~10
|
2026年
2月26日
|
|
AY-U22RS
|
6~7
|
6~9
|
※1 4畳~8畳相当の試験環境における1日~14日後の効果であり、実使用環境の実証結果ではありません。詳細は■主な特長以下をご確認ください。
※2 国内家庭用エアコンにおいて。超親水ナノコーティング技術によりファンのカビを除菌、速乾する技術(当社調べ)。<AY-U25RS/U22RS>2026年2月26日発売予定。<AY-U71RL2/U63RL2/U56RL2/U40RL2/U36RL/U28RL>2026年3月12日発売予定。
※3 国内家庭用エアコンと連携した生成AIによる応答サービスにおいて(当社調べ)。2026年2月26日サービス開始。
※4 ご利用には「COCORO HOME」のバージョンを最新にアップデートしたうえで対象機器の登録をおこなう必要があります。また、ご利用状況により、機能を制限させていただく場合がございます。ご利用にあたり個人情報や機密情報は入力しないでください。
※5 国内家庭用エアコン 2027年度目標省エネ基準達成モデルにおいて。2.5kW、2.2kWクラス 室内機高さ249mm。2026年1月27日現在(当社調べ)。
■ 主な特長
1.「防カビカラッとファン」とプラズマクラスター技術により、エアコン内部のカビを除菌
本シリーズの開発にあたり、エアコンの困りごとである「カビ」に着目しました。真菌類研究の権威である、県立広島大学の森永力名誉教授監修のもと検証をおこない、エアコン内部で特にカビが多く発生するのは「ファン」であることを解明しました。この結果を踏まえ、カビの増殖を抑制する「防カビカラッとファン」を新たに搭載。業界で初めて、ファンに「超親水ナノコーティング」を採用しました。本コーティングは、カビの除菌性能を有しており、加えてファンの表面に残った水分を薄く広げる超親水性により、乾燥時間を約60%短縮(※6)することで、カビ増殖の主な原因となる水分やホコリの付着を抑制。ファンのカビを除菌(※7)します。

県立広島大学 名誉教授/微生物工学、応用微生物学(専門)
森永 力(もりなが つとむ)氏のコメント
カビの増殖原因は「水分」と、炭素などの栄養を含んだ「ホコリ」です。カビの増殖を抑えるには、まず湿度(水分)対策が重要です。エアコンにおいては、特に冷房運転時に、内部の湿度が非常に高くなるため、カビが増殖しやすい環境にあります。今回、エアコン内部において、特にカビが多くひそむのは「ファン」であることがわかりました。そのファンの水分を速く乾かすことは、エアコン内部のカビ増殖を抑えるために、非常に有効な手段です。
※6 当社独自の条件により評価。テストピースに水滴5μLを滴下し、超親水ナノコーティング【なし/あり】における乾燥時間を比較。超親水ナノコーティング【なし】40分【あり】16分で乾燥。
※7 ●試験依頼先:(一財)日本食品分析センター ●試験成績書:第25119724001-0101号(2026年1月5日発行)●試験方法:当社試験室(8畳相当)の密閉試験空間にて、室温27℃、湿度70%の試験空間に「防カビカラッとファン」と、従来ファンを搭載した<AY-U36RL>を設置。それぞれのファンにカビを滴下し、3時間冷房運転した後のファン表面のカビの数を比較。■試験結果:1日後にカビが99.0%以上除去されていたことを確認。実使用空間での実証結果ではありません。
また、当社独自の空気浄化技術「プラズマクラスター」による機能で、エアコン内部のカビを除菌(※8※9)します。「プラズマクラスター内部清浄」は、運転停止後にルーバーを閉じた状態でファンを逆回転させることで、エアコン内部にイオンを充満させる新たな制御を加えました。エアコン運転停止中には「カビパトロール」を実施します。カビが発生しやすい環境になると、自動でファンを逆回転させます。新たに、ファンの逆回転数を上げることで、エアコン内部に放出するイオンの個数を向上しました。
「防カビカラッとファン」、「プラズマクラスター内部清浄」、「カビパトロール」でエアコン内部のカビに対策することで、エアコンから吹き出す風に含まれるカビを99.0%以上減少させます(※10)。
本シリーズは、赤ちゃんにとっても清潔で安心な空気をお届けするという想いを込め、「First Air~はじめての空気を、もっとやさしく~」をキーメッセージとして展開してまいります。

キーメッセージイメージ
「プラズマクラスター」運転あり・なしのカビの比較
※8 ●試験依頼先:(一財)日本食品分析センター ●試験成績書:第25078033001-0101号(2025年8月26日発行)●試験方法:当社試験室(8畳相当)の密閉試験空間にて、室温27℃、湿度70%の条件で、冷房運転を断続的に実施。<AY-U22RS>にて運転後に「プラズマクラスター内部清浄」をおこなった場合と、おこなわない場合で、カビを滴下した試験片のサンプルを試験依頼しカビの数を比較。■試験結果:3日後にカビが99.0%以上除去されていたことを確認。実使用空間での実証結果ではありません。
※9 ●試験依頼先:(一財)日本食品分析センター ●試験成績書:第25078033003-0101号(2025年8月26日発行)●試験方法:当社試験室(8畳相当)の密閉試験空間にて、室温27℃、湿度70%の条件でエアコンを設置。<AY-U22RS>にて「カビパトロール」(室内機内部)入の場合と、切の場合でカビを滴下した試験片のサンプルを試験依頼しカビの数を比較。■試験結果:2日後にカビが99.0%以上除去されていたことを確認。実使用空間での実証結果ではありません。
※10 ●試験依頼先:(一財)日本食品分析センター ●試験成績書:第25119724009-0101号(2026年1月5日発行)●試験方法:当社試験室(8畳相当)の密閉試験空間にて、室温27℃・湿度70%の条件で、冷房運転を8時間/日実施。<AY-U36RL>にて「防カビカラッとファン」、「プラズマクラスター内部清浄」、「カビパトロール」、プラズマクラスター設定全てありの場合と、なしの場合で、吹き出す風に含まれる浮遊カビ数を比較。■試験結果:14日後にカビが99.0%以上除去されていたことを確認。実使用空間での実証結果ではありません。
2.エアコンで初めて、生成AIサービスに対応
本シリーズは、エアコンで初めて生成AIサービスに対応しました。「COCORO HOME」アプリ内の「COCORO HOME AI」から、スマートフォンなどを用いて、手軽に使用できます。エアコンの使い方やお手入れ方法などの質問をテキストで入力すると、取扱説明書や製品FAQなどのデータベースをもとに自然な言葉で回答します。運転モードの提案時には、回答とともに設定画面に誘導してくれるので、簡単に変更できます。

左:「COCORO HOME AI」利用イメージ、右:「COCORO HOME AI」画面イメージ
3.新省エネ基準を満たしながら、設置性に優れたコンパクト設計<AY-U25RS/U22RS>
エアコンは、一般家庭における消費電力量において大きな割合を占めています。そのため、昨今の電気代や物価の高騰を受け、省エネに対するニーズが一段と高まっています。そうしたニーズに応え、本シリーズは、2027年度を目標とする新省エネ基準を全機種で達成しました。寝室など、小部屋での使用に適した<AY-U25RS/U22RS>では、本体の奥行と高さを抑えたコンパクトサイズに設計。新省エネ基準を満たしながら、2.5kW~2.2kWクラスにおいて、業界最小の高さ249mmを実現しました。

■ その他の特長
<AY-U71RL2~U28RL>の室内機のファンに、新たに「マルハナバチの羽根」の断面形状を応用した「ネイチャーテクノロジー」を採用しました。マルハナバチの羽根の断面は、先端が丸く平坦な形状をしています。羽根の周りの凹凸部分に渦を発生させることで、摩擦抵抗をなくし、空気の流れをなめらかにしています。ファンに、この羽根の形状を応用することで、渦の発生箇所を制御し、安定した空気の流れを実現。送風効率を、当社従来ファン搭載時と比べ、約4%向上(※11)させ、省エネ性を高めました。

※11 同一風量での運転時にかかった消費電力量を比較。新ファン搭載時:48W、従来ファン搭載時:50W。
■ 主な仕様<AY-U40RL2/U22RS>
|
形名
|
AY-U40RL2
|
AY-U22RS
|
|
色調
|
ホワイト系
|
|
電源
|
200V-20A
|
100V-15A
|
|
適用床面積(目安)
|
冷房:11~17畳(18~28m2) 暖房:11~14畳(18~23m2)
|
冷房:6~9畳(10~15m2) 暖房:5~6畳(8~10m2)
|
|
プラズマクラスター 適用床面積(目安)(※12)
|
約14畳(約23m2)
|
約6畳(約10m2)
|
|
消費電力
|
冷房:965W(120~1,700W) 暖房:1,100W(110~3,390W)
|
冷房:500W(110~970W) 暖房:600W(80~1,490W)
|
|
待機時消費電力
|
約0.5W
|
約0.4W
|
|
運転音
|
冷房:室内機 62dB / 室外機 60dB
暖房:室内機 68dB / 室外機 60dB
|
冷房:室内機 57dB / 室外機 59dB
暖房:室内機 60dB / 室外機 56dB
|
|
外形寸法
(幅×奥行×高さ)
|
室内機 798 × 387 × 295mm 室外機 800 × 300 × 630mm
|
室内機 798 × 301 × 249mm 室外機 670 × 280 × 540mm
|
|
質量
|
室内機 16kg / 室外機 35kg
|
室内機 11kg / 室外機 23kg
|
※12 製品を壁に設置し、風量最大運転時に部屋中央(床上1.2m)で25,000個/cm3以上のイオンが測定できる床面積の目安です。
● COCORO+(ココロプラス)ブランドマークおよびCOCORO HOME、COCORO AIRは、シャープ株式会社の登録商標または商標です。
● プラズマクラスターロゴ(図形)およびプラズマクラスター、Plasmaclusterは、シャープ株式会社の登録商標です。
● 「AIoT」は、AI(人工知能)とIoT(モノのインターネット)を組み合わせ、あらゆるものをクラウドの人工知能とつなぎ。人に寄り添う存在に変えていくビジョンです。「AIoT」はシャープ株式会社の登録商標です。
<シャープについて>
シャープは、110年以上にわたり、エレクトロニクスを中心に、多くの世界初・業界初の革新的な製品や技術を開発してきました。経営信条「二意専心 誠意と創意」に基づき、コーポレートスローガン「ひとの願いの、半歩先。」を定め、人々の「暮らす」と「働く」のあらゆるシーンに寄り添う独創的なモノやサービスを通じ、「新しい文化」を創造する企業を目指しています。